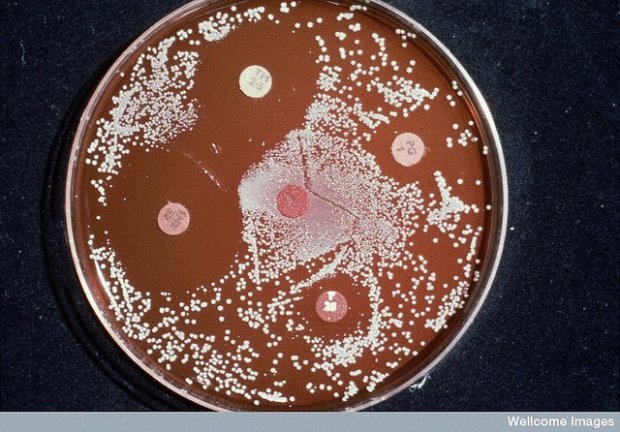
15382814664_35f94f7d0f_z

Crédits: Andrea Zampatti (HotSpot Media)
Ce matin sur CIBL, je vous parle de bananes et de chauves-souris, d’infections résistantes aux antibiotiques et de rats qui rient.
1er sujet : En cherchant un moyen de retarder le mûrissement des bananes, des scientifiques ont peut-être trouvé un moyen de sauver les chauve-souris.

Dispersion du syndrome du museau blanc (US Fish and Wildlife Service)
2e sujet : C’est la Semaine mondiale pour un bon usage des antibiotiques. Même si on les connait depuis moins d’un siècle, on aurait du mal à s’en passer. Mais quelle est notre compréhension réelle de l’« antibiorésistance » ?
Image: Wellcome Trust
3e sujet : Chatouiller des rats pour comprendre d’où vient le rire et à quoi il sert ? Oui, il s’agit bien d’une étude scientifique.